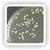

Short Course for Brewers
Our short courses for brewers are designed for individuals in the brewing and allied industries looking to improve their understanding of the scientific principles and practice of specific areas of the brewing process. They are also suitable for those aspiring to a career as a practical brewer.
We offer a wide range of courses covering disciplines across the brewing process from raw materials to beer maturation and filtration.
Courses Overview
Each course is delivered using a combination of interactive eLearning together with practical aspects which are taught during a 'week in residence' at the University at the end of Spring Semester each year. Dates for the week in residence courses will be posted under the student information section of this site up to a year in advance. You will have access to a library of electronic brewing resources as well as a personal tutor.
Available Courses

Brewing Raw Materials and Wort Production
(BIOS4154, 20 Credits)
This course focuses on the raw materials, practice and processes used to manufacture wort in a modern brewery. It develops understanding of the key quality factors of the principal raw materials and how these impact on the quality of wort produced in the brewing process. You will develop knowledge and specialist skills related to the unit operations used in wort production and how the technologies are controlled to meet the operational objectives of a modern brewhouse (such as production schedule, wort strength and fermentability specified for a brand, meeting environmental targets through minimising inputs of energy and water).
|

Brewery Yeast Management
(BIOS4034, 10 credits)
This course provides an understanding of the underlying science and technology of brewery yeast management. It considers brewing yeast taxonomy, genomics, genetic stability, storage protocols, yeast supply and propagation. Principles, best practice and quality assurance strategies are discussed.
|
Fermentation and Yeast Handling
(BIOS4035, 10 credits)
This course focuses on the principles and practice of fermentation management and subsequent yeast handling. It considers pitching and yeast quality, fermentation and flavour metabolism, fermentation systems and operations, yeast flocculation, cropping and storage. Operational practice and challenges as well as potential innovative technologies are discussed.
|

Beer Finishing and Packaging
(BIOS4156, 20 credits)
This course teaches the biological, chemical and engineering processes that are involved in transforming fermented beer into a wide range of finished beers as well as the principles and practice of packaging beers in small-pack and large-pack formats. Key topics include flavour maturation and allied industrial practices, beer stabilisation to prevent non-biological hazes, beer filtration, carbonation, packaging and pasteurisation. You will learn theoretical and legal aspects of packaging together with consideration of the design and operation of modern high speed packaging lines.
|

Sustainable Beer Production
(BIOS4037, 10 credits)
The sustainability of production is a critical topic for any brewer. This course will examine resource usage in brewing with a focus on Key Performance Indicators such as specific energy and water usage. The use of life cycle analysis (LCA), carbon foot printing and water foot printing as tools to achieve a more sustainable process will be discussed. There is also a focus on brewing co-product streams (e.g. effluent, recovered beer, spent grain, spent yeast, trub, cleaning-in-place residues and kieselguhr) and how these can be reduced and/or treated to minimise their impact on the environment. Other topics include the utilisation of solid waste (spent grains, yest and hops) to produce co-products and approaches to reduce packaging, which represents a significant part of the carbon footprint of beer.
|

Brewing Microbiology
(BIOS4038, 10 credits)
This course considers the occurrence, frequency, biology and detection of the micro-organisms that are associated with the spoilage of the brewing process from raw materials to final product. The impact of contamination on process and final product quality will be considered. The principles and practice of HACCP, cleaning-in-place and GMP will be discussed.
|

Beer Flavour Development and Sensory Analysis
(BIOS4157, 10 credits)
This course will develop your understanding of the main components of beer flavour, how and where in the process they are formed and the key controls and check-points required to ensure flavour quality and consistency. You will learn about the human senses and how flavour is perceived as well as contemporary techniques in sensory analysis and their application to beer. Flavour stability of beer in pack and commonly encountered undesirable taints are also covered as other important aspects of beer quality to the consumer.
|

Beer Analysis and Quality Management
(BIOS4040, 10 credits)
This course covers the development and management of a quality programme in a brewery with a strong emphasis on the analytical methods used. Quality governance, quality management and the key supporting functions (asset care, GMP, record keeping) are discussed. The decision process to determine what to test and which methods to be used are covered (HACCP, setting of specification, handling of process data). Supporting this is a virtual lab that covers the various methods used in beer analysis including their principles and methodology. The relevant accreditation programmes available are summarised.
|
The courses are taught by staff from the School of Biosciences who have expertise in brewing and related sciences, together with invited contributions from specialist brewing practitioners: all are internationally renowned leaders within their field.
Download Course Fees and Start Dates 2026-27 (PDF)
Please contact us to apply for the short courses